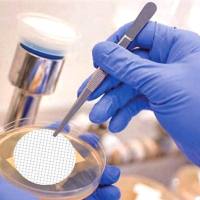
巴罗克-微生物检测膜

万千商家帮你免费找货
0 人在求购买到急需产品
- 详细信息
- 技术资料
- 库存:
有
- 供应商:
山东巴罗克生物科技股份有限公司
- 英文名:
Cell Scrapers & Lifters
- 规格:
100 个 / 箱 & 200 个 / 箱

细胞刮:
● 医疗级聚乙烯材质,高韧性,减少细胞损伤
● 柄长提供 18cm 和 25cm 选择,刮头灵活转动,
便于刮取大范围细胞
● 辐照灭菌,无致热源
● 独立纸塑包装,使用安全方便
细胞铲:
● 医疗级聚乙烯材质,高韧性,减少细胞损伤
● 铲头独特坡度设计,减少对细胞损伤
● 辐照灭菌,无致热源
● 独立纸塑包装,使用安全方便

| 产品型号 | 品名 | 柄长 | 灭菌 | 包装方式 | 包装规格 |
| 70-2180 | 细胞铲 | 18cm | 是 | 独立包装 |
100 个 / 箱
|
| 70-1180 | 细胞刮 | 18cm | 是 | 独立包装 |
100 个 / 箱
|
| 70-1250 | 细胞刮 | 24.3cm | 是 | 独立包装 |
200 个 / 箱
|



山东巴罗克生物科技股份有限公司是专业从事一次性医疗检验试剂和耗材、生命科学实验耗材和设备,以及生物样本库系统一体化服务等领域研发与生产的高新技术企业,拥有一批生命科学和医学领域的专业管理和技术人才,并始终以“服务人类健康事业”为宗旨,持续创新,不断进取,产品远销欧美亚非等数十个国家和地区,旗下BIOLOGIX和CryoKING品牌已在国内国际行业领域享有声誉。
公司着力核心产品技术研发和创新,拥有符合GMP标准的十万级无尘净化车间和多个专业研发检测实验室,已通过ISO9001、CE、FDA等产品和质量体系认证,并参照国际标准建立严格的产品质量控制体系,专心做高品质产品,不断增强产品技术含量,丰富产品种类,强化解决方案式系统化服务,逐步实现产品升级,提升企业核心竞争力。
风险提示:丁香通仅作为第三方平台,为商家信息发布提供平台空间。用户咨询产品时请注意保护个人信息及财产安全,合理判断,谨慎选购商品,商家和用户对交易行为负责。对于医疗器械类产品,请先查证核实企业经营资质和医疗器械产品注册证情况。
技术资料暂无技术资料 索取技术资料
巴罗克-细胞刮/细胞铲
询价